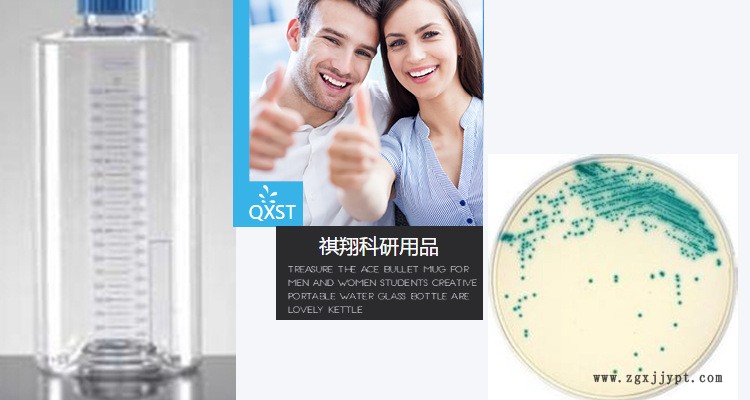
undefined

| 材質(zhì) | 四氟 |
|---|---|
| 成分 | 四氟 |
| 容量 | 100mL,蓋子,燒杯+蓋子 |
| 生產(chǎn)廠家 | 其他 |
| 允許誤差 | 0(ml) |
| 品牌 | 2176:20213,其他 |
| 型號(hào) | 100ml |
| 品名 | 四氟燒杯 | 規(guī)格 | 100ml |
| 包裝 | 材質(zhì) | 聚四氟乙烯 | |
| 顏色 | 白色 | 貨號(hào) | |
| 重量 | 用途 | ||
| 尺寸 |
| ||





![]() |
|
| 材質(zhì) | 四氟 |
|---|---|
| 成分 | 四氟 |
| 容量 | 100mL,蓋子,燒杯+蓋子 |
| 生產(chǎn)廠家 | 其他 |
| 允許誤差 | 0(ml) |
| 品牌 | 2176:20213,其他 |
| 型號(hào) | 100ml |
| 品名 | 四氟燒杯 | 規(guī)格 | 100ml |
| 包裝 | 材質(zhì) | 聚四氟乙烯 | |
| 顏色 | 白色 | 貨號(hào) | |
| 重量 | 用途 | ||
| 尺寸 |
| ||